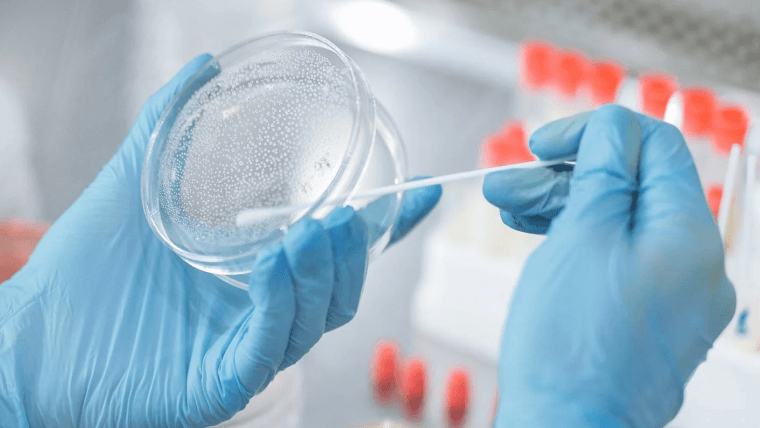

PDF Reader Pro 與 The Learning Hub
透過簡化文件解決方案,使The Learning Hub更加強大
了解 The Learning Hub 這間著名學術機構如何使用 PDF Reader Pro 的批量購買計畫來簡化其行政流程和文件管理

問題與挑戰
在使用 PDF Reader Pro 之前,The Learning Hub 一直處於繁重的紙本工作中,這些流程妨礙了員工和學生的效率和合作。
低效的紙本文件處理
員工和學生在手動分發和共享紙本文件時常遇到延遲狀況。
修訂追蹤問題
紙本文件很難追蹤修訂,繼而導致錯誤和誤解。
遠端聯繫受限
紙本文件系統限制了對文件的遠端互動。
PDF Reader Pro 提供什麼 解決方案?
注釋協作
使用直觀的注釋工具有效協作,提升教材的溝通和理解。
安全文件加密
透過高級加密和權限控制,保護敏感的學術文件,維護文件的完整性和隱私。
高效的數位簽名
使用更新的數位簽名簡化簽名流程,提高文件工作流程效率並確保具有法律效力的協議。
跨平台使用
確保在 Mac, Windows, iOS 和 Android 上,能獲取一致的文件管理,為靈活的學習環境搭橋。




實現顯著 成果
資料檢索時間
减少40%
减少40%
現在獲取資料的速度提高了40%,實現了更快速、更可靠的資訊檢索。
學生滿意
提高25%
提高25%
學生服務品質提升,滿意度評分成長了25%。
專案完成度
增加35%
增加35%
新工具提高了部門間的協作,專案完成率成長了35%。
我們的合作夥伴怎麼說
PDF Reader Pro 不僅簡化了我們的文件管理流程,還建立了我們與文件互動的新標準。

Agency Manager - 機構經理
成功案例
了解其他機構如何利用 PDF Reader Pro 克服他們在文件管理上遇到的挑戰。獲得與您類似的企業的見解。
聯繫我們

Support Chat
Support Chat